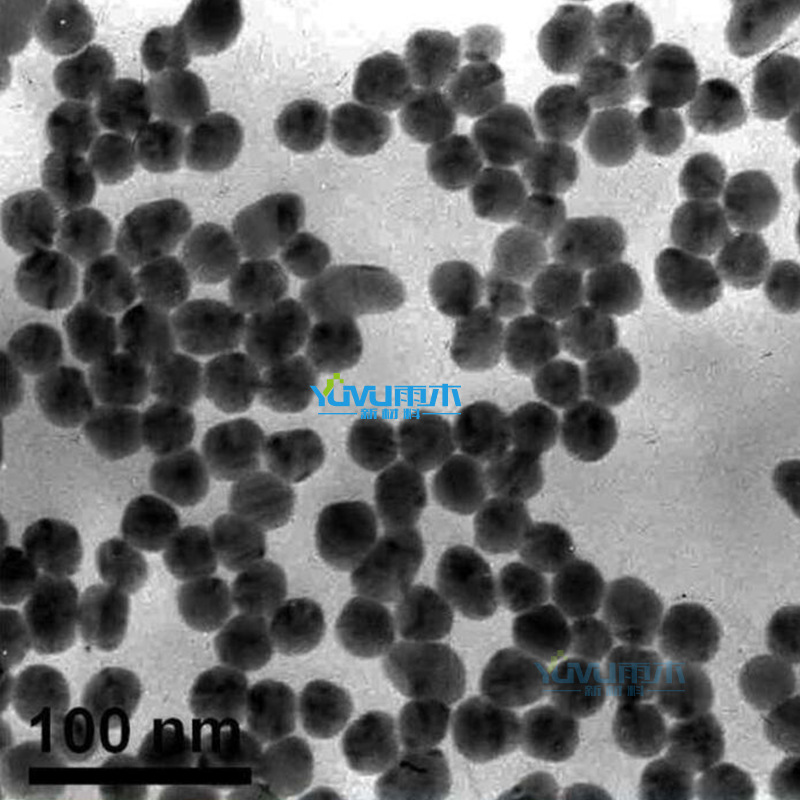
20240433.png

Порошок ванадия Микронный порошок ванадия Ультратонкий порошок ванадия Сферический порошок ванадия V Высокочистый порошок ванадия
Цена
¥50.00 / ≈ 602 ₽
MOQ: 1 pcs
1шт - ¥50.00
Продавец
雨木(宁波)新材料有限公司
Рейтинг
0
Продано
0
Всего
В наличии
80
SKU суммарно
Offer ID: 992905624846
Оформить заказ
Модель:
| Изображение | Модель | Цена (CNY / RUB) | В наличии | SKU ID | Кол-во / Корзина |
|---|---|---|---|---|---|
📦 | 500nm | ¥500.0 / ≈ 6 023 ₽ | 10 | 6129096914755 | |
📦 | 800nm | ¥480.0 / ≈ 5 782 ₽ | 10 | 6129096914756 | |
📦 | 1um | ¥470.0 / ≈ 5 661 ₽ | 10 | 6129096914757 | |
📦 | 5um | ¥450.0 / ≈ 5 421 ₽ | 10 | 6129096914758 | |
📦 | 10um | ¥430.0 / ≈ 5 180 ₽ | 10 | 6129096914759 | |
📦 | 20um | ¥400.0 / ≈ 4 818 ₽ | 10 | 6129096914760 | |
📦 | 25um | ¥385.0 / ≈ 4 638 ₽ | 10 | 6129096914761 | |
📦 | Contact customer service for detailed specifications and prices | ¥50.0 / ≈ 602 ₽ | 10 | 6129096914762 |
Статистика продавца
3.5
Сервис
Источник: API 1688
2.8
Логистика
Источник: API 1688
5.0
Споры
Источник: API 1688
1.6
Оформление
Источник: API 1688
2.0
Консультация
Источник: API 1688
8%
Повторные покупки
Источник: API 1688
4.3
Постпродажное
Источник: API 1688
25%
Возврат по качеству (30д)
Источник: API 1688
Свойства товара
Бренд Ym-v-05
Номер товара Ym-v-05
Происхождение Zhejiang
Содержание ванадия ≥ 99.9
Содержание примесей 0.01
Вес 1
Бренд Rain wood
Описание товара